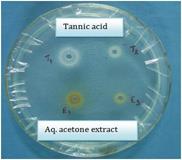
5
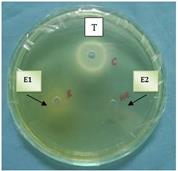
7

Int J Pharm Pharm Sci, Vol 7, Issue 10, 170-175Original Article
ISOLATION AND QUANTIFICATION OF TANNINS FROM THE ROOT BARK OF CLERODENDRUM INFORTUNATUM LINN. AND ASSESSMENT OF THEIR ANTIOXIDANT POTENTIAL AND ANTIPROLIFERATIVE EFFECT ON HCT-15 CELLS
LAL RAISA HELEN, M. JYOTHILAKSHMI, M. S. LATHA
School of Biosciences, Mahatma Gandhi University, P. D. Hills P. O, Kottayam, Kerala, India 686560
Email: mslathasbs@yahoo.com
Received: 26 May 2015 Revised and Accepted: 08 Aug 2015
ABSTRACT
Objective: Clerodendrum infortunatum is a traditional Indian medicinal plant which has been used for the treatment of many diseases. The root bark juice is effective against indigestion and abdominal pain. Based on the preliminary screening study on the antioxidant activity of the plant, the present study was aimed to isolate tannins from the root bark of Clerodendrum infortunatum and it was qualitatively analysed and quantified. The in-vitro antioxidant activity and antiproliferative effect on HCT-15 cell lines was also evaluated.
Methods: Tannins were isolated from the root bark of Clerodendrum infortunatum. It was qualitatively analysed by phytochemical screening, protein precipitation test and thin layer chromatography (TLC) and quantified by Folin-denis assay and protein precipitation assay. The modified method of protein precipitation assay was carried out to differentiate between condensed and hydrolysable tannins. Antioxidant and antiproliferative activity were also evaluated.
Results: Phytochemicalscreening revealed the presence of tannins. TLC and protein precipitation ability of the extract confirmed the presence of tannins. The total tannin content by Folin-denis assay was found to be 166.6±5.607 mg tannic acid equivalents/g dry extract. This coincides with the radial diffusion method (163.75±7.5 mg tannic acid equivalents/g dry extract). Isolated tannins exhibited significant antioxidant and radical scavenging activities compared to the standard antioxidant ascorbic acid. 3-(4, 5 dimethylthiazol-2-yl)-2, 5-diphenyl tetrazolium bromide (MTT) assay demonstrated the antiproliferative effect of isolated tannins against HCT-15 cell lines and about 50% of the cells were found to be dead at a concentration of 100 µg/ml.
Conclusion: The antioxidant and antiproliferative properties exhibited by tannins isolated from Clerodendrum infortunatum suggest it as a new source of medicament.
Keywords: Clerodendrum infortunatum, Verbenaceae family, Hydrolysable tannins, Antiproliferative effect, Colon cancer, Thin layer chromatography.
© 2016 The Authors. Published by Innovare Academic Sciences Pvt Ltd. This is an open access article under the CC BY license (http://creativecommons.org/licenses/by/4.0/)
INTRODUCTION
Clerodendrum infortunatum Linn. Commonly known as Hill glory bower is a gregarious terrestrial shrub belonging to the family Verbenaceae. The plant is widely distributed throughout the plains of India. The roots, tender branches, leaves, flowers and seeds have medicinal properties [1]. Various parts of the plant have been used by the tribes in colic, scorpion sting and snake bite. Fresh juice of leaves has been used as a vermifuge and as bitter tonic and febrifuge in malaria [2]. The roots are externally applied for tumors and skin diseases. Root relieves congestion and torpidity of the bowels. The plant has also been used in the treatment of bronchitis, asthma, fever, inflammation and epilepsy. Besides its medicinal properties, the extracts are used as fumigants to deter mosquitoes and bed bugs [3, 4]. In our previous study on the in-vitro antioxidant activity of the plant, acetone extract of the root bark was found to exhibit the highest antioxidant activity [5]. Phytochemical analysis revealed the presence of tannins and phenolics in the acetone extract. This study is focussed on tannins from the root bark of Clerodendrum infortunatum.
Tannins are naturally occurring high molecular weight water soluble polyphenolic compounds. They are distinguished by their ability to bind and precipitate proteins [6]. Tannins occur in the leaf, root, wood, bark, fruit and bud of plants and are divided into condensed tannins (CT) and hydrolysable tannins (HT). Hydrolysable tannins are further grouped into gallotannins and ellagitannins [7]. Certain species of gymnosperms and monocots produce only CT, whereas dicots can produce either CT or HT or a mixture of both tannins [8]. Many studies have reported that they are astringent polyphenols which reduce the digestibility and nutritional quality of herbivore diets [9, 10]. However, tannins from different plants were reported to demonstrate pharmacological activities also. The natural ability of the plant to defend itself from predation and infections is linked to the presence of tannins which may be due to the complex formation between tannins and proteins [11]. The antioxidant [12], anti-inflammatory [13], anticancer [14] and antimicrobial [15] activities of tannins from various sources have been reported.
Based on the preliminary study and available literature, the present study was aimed to isolate tannins from the root bark of Clerodendrum infortunatum and to study its antioxidant potential and antiproliferative effect on HCT-15 cell lines.
MATERIALS AND METHODS
Chemicals
1,1-diphenyl-2-picrylhydrazyl (DPPH), 2,4,6-tri(2-pyridyl)-s-triazine (TPTZ), 3-(4, 5 dimethylthiazol-2-yl)-2, 5-diphenyl tetrazolium bromide (MTT), ascorbic acid, tannic acid and hydroxylamine hydrochloride were purchased from Sigma, USA. Ferrous sulphate, sodium acetate, and ammonium molybdate were purchased from Merck (India). Silica gel G, bovine serum albumin (BSA) and agarose were purchased from SRL chemicals (India). All other chemicals used were of analytical grade.
Collection of plant
The root bark of Clerodendrum infortunatum was collected from the Idukki District of Kerala during the month of April 2013. It was washed properly, air dried in shade, chopped and powdered in a kitchen blender. The powdered material was stored in air tight containers until use.
Isolation of tannins
About 80 g of dried and powdered root bark was defatted with petroleum ether in a mechanical shaker for 48 h at room temperature. It was then extracted with aqueous acetone (70% acetone) for 60 min at 60 °C in a water bath with constant stirring. The mixture was then filtered and centrifuged at 3000 rpm for 10 min. The supernatant was allowed to evaporate at room temperature. The acetone free extract was lyophilized (Lark, Penguin Classic Plus, Chennai). The powder was collected, weighed and percentage yield was calculated and stored in sterile bottles at 4 °C in a refrigerator for further studies.
Qualitative analysis of isolated tannins
Phytochemical analysis
Phytochemical screening of aqueous acetone extract of the root bark of Clerodendrum infortunatum was carried out using standard protocols [16-18].
Protein precipitation test
Tannin after reaction with albumin produces an opaque precipitate which can be visualised in the form of a disc in an agarose gel [19]. A solution of 50 mM acetic acid and 60 mM ascorbic acid was used for preparation of the gel, adjusting the pH to 5 with the addition of sodium acetate, which was added in 1% agarose (type I). Subsequently the mixture was brought to heat, stirring until boiling point so that there was complete homogenization of agarose. After cooling (45 °C), the mixture was added to fatty acid free bovine serum albumin (BSA) fraction V at a concentration of 0.1%. Aliquots of 10 ml were distributed in petri dishes that were placed on a level surface to which they were formed uniform layers of the gel. After total solidification, wells were made which are 2 cm distant from each other and about 50 µl of the extract was added directly into the wells. The plates were then sealed with parafilm and incubated at 30 °C for 120 h.
Thin layer chromatography
Thin layer chromatographic analysis (TLC) of the aqueous acetone extract was performed according to the method described by Lea [20]. An aliquot of the sample (10 mg/ml) was applied to the silica gel G coated (2.5 g/10 ml) glass plates which were dried and activated at 100 °C for 30 min. Toluene: Acetone: Formic acid in the ratio 60:60:10 was used as the mobile phase. Tannic acid was used as the reference compound. Tannic acid is β-Penta-O-galloyl-D-glucose and it is the model compound for hydrolysable tannins [21]. The developed plates were air dried and placed in a chamber saturated with iodine vapours to observe the spots. In the given solvent system, tannin stays at the origin whereas other phenolic migrate. Tannic acid gives multiple spots corresponding to various degrees of esterification.
Quantitative analysis of isolated tannins
Folin-denis assay
Total tannin content was measured by Folin-denis method [22] which is based on the reducing power of the phenolic hydroxyl group of tannins. To 2 ml of the extract an equal volume of Folin-denis reagent was added. The contents were mixed thoroughly and after 3 min 2 ml of 1 N sodium carbonate was added. The mixture was mixed well and kept at room temperature for 1 h for colour development. The optical density of the resultant solution was read at 700 nm.
Protein precipitation assay
The tannins were quantified by the modified method of Hangerman’s radial diffusion [19].The protein precipitation test is performed with different concentrations (10, 25, 50, 100 mg/ml) of tannins. Tannin after reaction with albumin produces an opaque precipitate in the form of a disc from which the diameter squared is proportional to its concentration. To construct the standard curve, different concentrations of tannic acid (5, 10, 15, 20, 25 mg/ml) were used and the result was expressed as mg tannic acid equivalents.
Selective determination of condensed or hydrolyzable tannins with radial diffusion
A modification of the radial diffusion method as described by Hagerman et al., (1997) distinguishes condensed tannins from hydrolyzable tannins based on the structural difference between them. The characteristic ester bonds in hydrolyzable tannins are susceptible to hydroxylaminolysis [23]. For the assay, 25 µl of the extract was placed into screw capped tube and added 300 µl hydroxylamine reagent (2 M hydroxylamine hydrochloride in ethanol: water (48/52, v/v). It was heated at 70 °C for 48 h. After incubation 50 µl of the sample was then added to the radial diffusion plates. 25 µl of the extract added to 300 µl distilled water serves as the control. The radial diffusion plates were sealed and incubated at 30 °C for 120 h. After incubation the plates were observed for rings of precipitation and diameter of the rings were measured.
In-vitro antioxidant assays
Reducing power
The reducing power of isolated tannins was determined by the method [22]. 2.5 ml of tannins (20-200 µg) was mixed with 2.5 ml phosphate buffer (0.2 M, pH 6.6) and 2.5 ml potassium ferricyanide (1%). The mixture was kept in a water bath at 50 °C for 20 min. After cooling, 2.5 ml of trichloroacetic acid (10%) was added and centrifuged at 3000 rpm for 10 min, whenever necessary. The upper layer of solution (2.5 ml) was mixed with 2.5 ml distilled water and 0.5 ml of freshly prepared ferric chloride solution (0.1%). The absorbance was read at 700 nm. Ascorbic acid at various concentrations (5-50 µg) was used as standard.
Free radical scavenging activity
The free radical scavenging potential of tannins was determined by using 1,1-diphenyl-2-picrylhydrazyl (DPPH) by the modified method [24]. 2 ml reaction mixtures containing 1 ml methanolic solution of DPPH (0.1 mM) and 1 ml of standard ascorbic acid and isolated tannins at various concentrations (1000-1.95 µg) were incubated in dark at 37 °C for 30 min. 1 ml of dimethyl sulfoxide (DMSO) served as the control. After incubation the absorbance was read at 517 nm. Radical scavenging activity was expressed as the inhibition percentage and can be calculated using the formula
% inhibition of DPPH radical = ![]()
IC50 value was calculated using the graph by plotting inhibition percentage against extract concentration.
Total antioxidant activity
The total antioxidant activity of the tannins was determined by the phosphomolybdenum method [25]. 0.1 ml of the extracts (100 µg) was mixed with 1 ml of the reagent solution (0.6 M sulphuric acid, 28 mM sodium phosphate and 4 mM ammonium molybdate). The tubes were capped and incubated at 95 °C for 90 min. After cooling the samples to room temperature, the absorbance was measured at 695 nm against a blank in a UV-Vis spectrophotometer (Hitachi U-500). 0.1 ml of ascorbic acid (5-30 µg) serves as the standard. The antioxidant activity was expressed as mg ascorbic acid equivalents per gram of sample on a dry weight basis.
Ferric reducing antioxidant power (FRAP) assay
Ferric reducing ability of the isolated tannins was estimated by the ferric reducing power assay [26]. 0.2 ml of the extract was added to 3 ml of FRAP reagent (10 parts of 300 mM sodium acetate buffer (pH 3.6), 1 part of 10 mM TPTZ solution and 1 part of 20 mM FeCl3.6H2O solution) and the reaction mixture was incubated at 37 °C for 30 min. The increase in absorbance at 593 nm was measured. FeSO4 (0.002-0.02 mmol/ml) was used as the standard. The antioxidant capacity of tannins based on the ability to reduce ferric ions was calculated from the linear calibration curve and expressed as mmol FeSO4 equivalents per gram dry extract. Ascorbic acid was used as the positive control.
Antiproliferative effect of tannins
The in-vitro antiproliferative effect of tannins was determined in colon cancer cell line HCT-15. HCT-15 cell lines were purchased from NCCS Pune and was maintained in Dulbecco’s modified eagles media (HiMedia) supplemented with 10% fetal bovine serum (Invitrogen) and grown to confluency at 37 °C in 5 % CO2 (NBS, Eppendorf, Germany) in a humidified atmosphere in CO2 incubator. The cells were trypsinized (500 µl of 0.025% trypsin in PBS/0.5 mM ethylene diamine tetra acetic acid solution (HiMedia)) for 2 min and passed to T flasks in complete aseptic conditions. Isolated tannins were added to the grown cells at a concentration of 10 µg, 50 µg and 100 µg from a stock of 10 mg/ml and incubated for 24 h. Untreated cells serve as the control. The % difference in viability was determined by standard MTT assay after 24 h of incubation.
MTT assay
The tetrazolium based colorimetric assay (MTT assay) was used to measure the viable cell growth [27]. The cell culture suspension was washed with 1x PBS and then added 30 µl of MTT solution to the culture (MTT-5 mg/ml dissolved in PBS). It was then incubated at 37 °C for 3 h. MTT was removed by washing with 1x PBS and 200 µl of DMSO was added to the culture. It was then incubated at room temperature for 30 min until the cell got lysed and colour was obtained. The solution was transferred to centrifuge tubes and centrifuged at top speed for 2 min to precipitate the cell debris. Optical density was read at 540 nm using DMSO as blank. Percentage viability was calculated as,
% viability = OD of test/OD of control X100
RESULTS AND DISCUSSION
Qualitative analysis
Percentage yield
The percentage yield of the aqueous acetone extract of the root bark of Clerodendrum infortunatum was found to be 1.5%.
Phytochemical analysis
The phytochemical screening of aqueous acetone extract of the root bark showed the presence of tannins and phenols (Table1). Plants have free radical scavenging molecules such as vitamins, terpenoids, phenolic acids, tannins, flavonoids, quinones, coumarins and alkaloids that have promising antioxidant properties [28]. These compounds make plants rich sources of drugs.
Table 1: Phytochemical constituents of aqueous acetone extract of the root bark of Clerodendrum infortunatum Linn
Phytoconstituents |
Aqueous acetone extract of the root bark |
Alkaloids |
- |
Flavonoids |
- |
Steroids |
- |
Diterpenes |
- |
Glycosides |
- |
Saponins |
- |
Tannins |
+ |
Phenols |
+ |
‘+’indicates the presence and ‘-’ indicates the absence of phytochemicals.
Protein precipitation test
Opaque precipitate was observed in the form of a ring around the wells treated with aqueous acetone extract (fig. 1). The ability to precipitate proteins is the defining characteristics of tannins. They can cross-link with fibrous protein due to their polymeric nature. Opaque precipitate confirmed the presence of tannins in the root bark [19].
Thin layer chromatography
The spot containing aqueous acetone extract remained at the origin when the TLC plates were developed in toluene: acetone: formic acid (60/60/10) as mobile phase and fumigated with iodine vapour (fig. 2). The reference compound tannic acid migrated from the origin and it can, be visualised as discrete bands. This confirmed tannins as the phytochemical component present in the aqueous acetone extract [20, 21].
Fig. 1: Protein precipitation test

T1-Spot containing aqueous acetone extract, T2-Tannic acid
Fig. 2: TLC of the aqueous acetone extract and tannic acid
Quantitative analysis
Folin-denis assay
The amount of tannin was quantified by Folin-denis assay and was expressed as mg tannic acid equivalent/g dry extract. The absorbance of aqueous acetone extract increased with increase in concentration. This is in accordance with the tannic acid standard. The total tannin content of the aqueous acetone extract was found to be 166.6±5.607 mg tannic acid equivalents/g dry extract.
Radial diffusion method
The extracts at all concentrations precipitated proteins in the gel which can be viewed as ring around the wells. The diameter of the rings seemed to be increased with increase in concentration of the extract. From the standard curve of tannic acid, the amount of tannin in the extract was found to be 163.75±7.5 mg tannic acid equivalents/g dry extract.
Selective determination of condensed or hydrolysable tannins
Tannins possess immense structural variability and are classified into hydrolysable tannins and condensed tannins based on their hydrolytic reaction with mineral acids and enzymes and the nature of phenolic nuclei involved in the tannins structure. In the modified method of radial diffusion, ring of precipitation was not observed in the extract treated with hydroxylamine hydrochloride reagent whereas the untreated extract showed ring of precipitate around the well (fig. 3).Treatment of hydrolysable tannins with hydroxylamine hydrochloride resulted in the hydrolysis of ester bonds, which then decomposed into core polyols and hydroxamates of the phenolic acids (gallic acid and ellagic acid). These phenolics cannot precipitate proteins in the radial diffusion method. Condensed tannins are unaffected by hydroxylaminolysis [23]. This indicated the presence of hydrolysable tannins in the extract.
Antioxidant assays
The antioxidant and scavenging properties of tannins isolated from the root bark of Clerodendrum infortunatum were studied. A large number of diseases are caused due to the deleterious effects of free radicals and reactive oxygen and nitrogen species. Antioxidants scavenge these molecules before they attack the body and thus protect from diseases. Currently the interest in natural antioxidants has increased due to the toxicity associated with the synthetic drugs [29].
E1-before hydroxylaminolysis, E2-after hydroxylaminolysis, T-tannic acid
Fig. 3: Radial diffusion of isolated tannins before and after hydroxylaminolysis compared to tannic acid
Reducing power
Isolated tannins exhibited significant reducing power which increased with increasing concentration. Fig. 4 shows the dose-response curve for the reducing power of the tannins. The reducing power of tannins may be due to the presence of hydroxyl group of phenols, which possess hydrogen donating abilities [30]. It was previously reported that phenolic compounds scavenge free radicals by an electron-transfer mechanism [31].

Ascorbic acid is diluted 1:4. Values are the mean±SD, where n=4. A-Ascorbic acid, B-Tannins
Fig. 4: Reducing power of isolated tannins and ascorbic acid
DPPH radical scavenging activity
The radical scavenging activity of tannins was determined by using DPPH as substrate. The decrease in the purple colour of DPPH indicated an increase in free radical scavenging activity. Thus isolated tannins exhibited concentration dependent radical scavenging activity (fig. 5). The percentage inhibition of DPPH radical increases over the concentration range of 1.95-31.25 µg/ml, equivalent to 1.95-31.25 µg/ml of ascorbic acid. The IC50 value of tannins also points to its antioxidant potential (table 2). The effect of antioxidant in DPPH can be attributed to its hydrogen donating ability [32].
Total antioxidant activity
Isolated tannins showed effective antioxidant activity which was found to be 242.5±8.216 mg ascorbic acid equivalents/g dry extract. Antioxidant activity of tannins may be due to the presence of phenolic groups. Polyphenolic compounds were reported to exhibit antioxidant activity, which may be due to redox properties, hydrogen donors and singlet oxygen quenchers which are involved in absorbing and neutralizing free radicals [33]. Tannins were previously reported to possess significant antioxidant activity [34].

Values are the mean±SD, where n = 4. A-Ascorbic acid, B-Tannins
Fig. 5: DPPH radical scavenging activity of isolated tannins and ascorbic acid
Table 2: IC50 value of isolated tannins and ascorbic acid
Antioxidant |
IC50 value (µg/ml) |
Ascorbic acid |
13.48±0.392 |
Tannins |
20.708±1.497 |
Values are the mean±SD (n=4).
Ferric reducing ability
The ferric reducing ability of tannins was estimated by the redox linked reaction. Antioxidants act as the reductants and reduce the ferric tripyridyltriazine to the ferrous complex of intense blue colour and it was expressed as mmol equivalents of FeSO4 and calculated from the standard plot of FeSO4. This is a pH dependent reaction. The reducing ability of tannin was found to be 314.67±13.57 mmol FeSO4 equivalents per gram dry extract, although it was less when compared to ascorbic acid (table 3). This indicated that they were capable of donating electrons to the free radicals to make them stable.
Table 3: Ferric reducing ability of tannins
Extract |
Antioxidant activity (mmol FeSO4 equivalents per gram dry extract |
Ascorbic acid |
610.83±13.57 |
Tannins |
314.67±9.44 |
Values are the mean±SD (n=4).
Antiproliferative effect of tannins against colon cancer cell lines
Cancer remains one of the world’s leading causes of death. Colon cancer, also known as colorectal or bowel cancer, which is characterized by uncontrolled cell growth in colon and rectum, is the third most common kind of cancer. Due to the lack of effective chemotherapeutic agents and the side effects associated with the existing ones, the search for alternative products from natural sources begins. The exposure of colon cancer cells to tannins exhibited significant reduction in the conversion of MTT as evident from the decrease in absorbance. The cleavage of tetrazolium ring in MTT involves mitochondrial succinate dehydrogenase and depends on the activity of respiratory chain and redox state of mitochondria [35]. The number of viable cells decreases with increase in concentration of the isolated tannins. At a concentration of 100 µg/ml, more than half of the cells were found to be dead by the cytotoxic effect of tannins (fig. 6). The cells were examined under the microscope and found to possess structural features that characterize the loss of viability. All the treated cells exhibited different levels of cytotoxicity. Cell shrinkage, aggregation, cell rounding and cell death was visible, depending upon the concentration (fig. 7). The cell was found to be detached from the surface. These morphological changes also points to the cytotoxic effects of tannins.
|
|
a) Control (HCT-15 cell line) |
b) HCT-15 cells treated with 10µg/ml tannin |
|
|
c)HCT-15 cells treated with 50µg/ml tannin |
d) HCT-15 cells treated with 100µg/ml tannin |
Fig.7: HCT-15 cell lines treated with tannins at different concentrations

Values are the mean±SD (n=4).
Fig. 6: Effect of tannins on the viability of HCT 15 cancer cell lines
CONCLUSION
Tannins isolated from the root bark of Clerodendrum infortunatum possessed significant antioxidant activity. The results were compared with a known antioxidant, ascorbic acid. Reducing power of tannins increased with increasing concentration. They exhibited the ability to scavenge DPPH radical and significant total antioxidant activity. Free radicals are involved in the pathogenesis of many diseases and thus free radical scavengers can provide the protective effect from such conditions. In this view, the antiproliferative effect of tannins was evaluated and it exhibited significant cytotoxicity against HCT-15 cell lines. Thus tannins from the root bark of Clerodendrum infortunatum may act as a source of natural antioxidant and an anticancer agent.
ACKNOWLEDGEMENT
The authors are thankful to Mahatma Gandhi University, Kottayam, Kerala for providing the necessary facilities for this work.
CONFLICT OF INTERESTS
Declare None
REFERENCES
- Das B, Pal D, Haldar. A review on biological activities and medicinal properties of Clerodendrum infortunatum Linn. Int J Pharm Pharm Sci 2014;6:41-3.
- Raghavan VG. Comprehensive Medicinal Plants. Vol 2. Houston, Texas: Stadium press LLC; 2011.
- Ghosh D. Bhant-A weed having multifarious medicinal properties. Sci Cult 2012;78:174-6.
- Varier PS. Indian Medicinal Plants-a compendium of 500 species. Vol 1. Hyderabad: Orient Longman; 1994.
- Helen LR, Jyothilaksmi M, Latha MS. Phytochemical and antioxidant screening of various extracts of the root bark and leaf of Clerodendrum infortunatum Linn. Pharmacophore 2014;5:343-51.
- Moosophin K, Wetthaisong T, Seeratchakot L, Kokluecha W. Tannin extraction from Mongosteen peel for protein precipitation in wine. KKU Res J 2010;15:377-85.
- Dai J, Mumper RJ. Plant phenolics: extraction, analysis and their antioxidant and anticancer properties. Molecules 2010;15:7313-52.
- Kraus TEC, Dahlgren RA, Zasoski RJ. Tannins in nutrient dynamics of forest ecosystems-a review. Plant Soil2003;256:41–66.
- Hagerman AE, Klucher KM. Chemistry of tannin–protein complexation. In: Cody V, Middletown E, Harborne J. editors. Plant flavonoids in biology and medicine: biochemical, pharmacological and structure activity relationships. New York: Alan R. Liss, Inc; 1986. p. 67–76.
- Rothman JM, Dusinberre K, Pell AN. Condensed tannins in the diets of primates: a matter of methods. Am J Primatol2009;71:70–6.
- Scalbert A. Tannins in woods and their contribution to microbial decay prevention. In: Hemingway RW. Laks PE. editors. Plant Polyphenols. New York: Plenum Press; 1992.
- Ujwala W, Vijender S, Mohammad A. In vitro antioxidant activity of isolated tannins of alcoholic extract of dried leaves of Phyllanthus Amarusschonn and Thonn. Int J Drug Dev Res 2012;4:274-85.
- Mota ML, Thomas G, Barbosa FJM. Antiinflammatory actions of tannins isolated from the bark of Anacardium occidentale L. J Ethnopharmacol1985;13:289-300.
- Chung KT, Wong TY, Wei CI, Huang YW, Lin Y. Tannins and human health: a review. Crit Rev Food Sci 1998;38:421-64.
- Doss A, Mubarack HM, Dhanabalan R. Antibacterial activity of tannins from the leaves of Solanum trilobatum Linn. Indian J Sci Technol 2009;2:41-3.
- Harborne JB. Phytochemical methods. London: Chapman and Hall Ltd; 1973.
- Trease GE, Evans WC. Pharmacognosy. 11 th ed. London: Bailliere Tindall; 1989.
- Tiwari P, Kumar B, Kaur M, Kaur G, Kaur H. Phytochemical screening and Extraction: a review. Int Pharm Sci 2011;1:98-106.
- Siqueira CFQ, Cabral DLV, Sobrinho TJSP, Amorim ELC, Melo JG, Araujo TAS, et al. Levels of tannins and flavonoids in medicinal plants: Evaluating bioprospecting strategies. Evidence-Based Complementary Altern Med 2011;2012:1-7.
- Lea AGH, Arnold GM. The Phenolics of ciders: bitterness and astringency. J Sci Food Agric 1978;29:478-83.
- Haslam E. Plant polyphenols: vegetable tannins revisited. In: Phillipson JD, Ayres DC, Baxter H. editors. Chemistry and pharmacology of natural products. Cambridge: Cambridge University Press; 1989. p. 230.
- Oyaizu M. Studies on products of browning reactions: antioxidative activities of products of browning reaction prepared from glucosamine. Jap J Nutr 1986;44:307-15.
- Hagerman AE, Zhao Y, Johnson S. Methods for determination of condensed and hydrolysable tannins. In: Shahadi F. editor. Antinutrients and phytochemicals in foods. Washington, DC: American Chemical society; 1997. p. 209-22.
- Blois MS. Antioxidant determination by the use of a stable free radical. Nature 1958;29:1199-200.
- Prieto P, Pineda M, Aguilar M. Spectrophotometric quantitation of antioxidant capacity through the formation of a phosphomolybdenum complex: Specific application to the determination of vitamin E. Anal Biochem 1999;269:337–41.
- Benzie IF, Strain JJ. The ferric reducing ability of plasma (FRAP) as a measure of “antioxidant power” the FRAP assay. Anal Biochem 1996;239:70-6.
- Arung ET, Shimizu K, Ryuichiro K. Inhibitory effect of isoprenoid-substituted flavonoids isolated from Artocarpus heterophyllus on melanin biosynthesis. Planta Med 2006;72:847-50.
- Aiyegro OA, Okoh AL. Preliminary phytochemical screening and in vitro antioxidant activities of the aqueous extract of Helichrysum longifoliumDC. BMC Complement Altern Med 2010;10:1-8.
- Saeed N, Khan MR, Shabbir M. Antioxidant activity, total phenolic and total flavonoid contents of whole plant extracts Torilis leptophyla L. BMC Complement Altern Med2012;12:1-12.
- Halliwell B, Gutteridge JMC. Free radicals in biology and medicine. 4th ed. Oxford UK Clarendon Press; 2007.
- Ak T, Gulcin I. Antioxidant and radical scavenging properties of curcumin. Chem Biol Interact 2008;174:27-37.
- Que F, Mao L, Zhu C, Xie G. Antioxidant properties of Chinese yellow wine, its concentrate and volatiles. LWT Food Sci Technol 2006;39:111-7.
- Omoruyi BE, Bradley G, Afolayan AJ. Antioxidant and phytochemical properties of Carpobrotus edulis (L.) bolus leaf used for the management of common infections in HIV/AIDS patients in eastern cape province. BMC Complement Altern Med 2012;12:2-9.
- Ujwala W, Vijender S, Mohammad A. In vitro antioxidant activity of isolated tannins of alcoholic extract of dried leaves of Phyllanthus Amarusschonn and Thonn. Int J Drug Dev Res 2012;4:274-85.
- Sathiya M, Muthuchelian K. Anti-tumor potential of total alkaloid extract of Prosopis juliflora DC leaves against Molt-4 cells in-vitro. Afr J Biotechnol 2011;10:8881-8.



